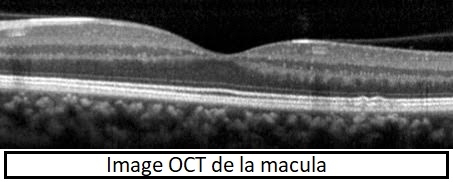

autres rubriques :
Qu’est-ce que la DMLA ?
La DMLA ou dégénérescence maculaire liée à l’âge correspond au vieillissement pathologique du centre de la rétine. Il s’agit d’un problème de santé publique et c’est la 3ème cause mondiale de déficience visuelle.
Un œil est un globe tapissé par la rétine. La macula est la zone centrale de la rétine, zone commune à tous, qui permet la vision fine (en bleu sur la photo ) Lorsque cette macula vieillit, des déchets s’accumulent, on les appelle les drusens (flèches bleues sur les photos). On parle alors de MLA (maculopathie liée à l’âge).
Cet état n’est pas une maladie, mais simplement le résultat d’un vieillissement (comme les rides sur la peau). Il est nécessaire de surveiller ces dépôts, car ils peuvent se compliquer et devenir alors DMLA, véritable dégénérescence pathologique.
Peut-on traiter la DMLA ?
Deux formes de DMLA existent :
- la forme sèche qui évolue lentement, pour laquelle aucun traitement n’existe encore.
- la forme humide d’évolution plus rapide, qu’on arrive à stabiliser avec les injections dans l’œil (IVT : injections intra vitréennes). Les flèches bleues montrent les dépôts (drusens) et les flèches oranges montrent une hémorragie et un infiltrat blanc correspondant à une image typique de DMLA humide visible sur le fond d’œil.
Qui est concerné par la DMLA ?
Essentiellement les plus de 50 ans. Les autres facteurs de risque sont le tabagisme et les antécédents familiaux.
Les signes qui doivent alerter ?
Une tache sombre au centre de la vision ou des vagues dans les lignes de livres ou le carrelage qui ondule. En général, les deux yeux sont touchés, mais de façon asymétrique.
Comment diagnostiquer la DMLA ?
En présence de ces symptômes, il faut consulter en urgence. Nos secrétaires ont la consigne de vous donner un RDV dans la semaine.
Dans un premier temps, vous serez interrogés par nos assistants, les orthoptistes/optométristes. Une mesure de votre vision sera effectuée, des collyres vous seront instillés pour permettre au médecin de faire un examen du fond d’œil.
Ces collyres vont dilater vos pupilles donc prévoyez d’être accompagné.
Enfin un minimum d’examens complémentaires nécessaires au diagnostic seront pratiqués tels qu’une photographie du fond d’œil et une OCT (tomographie par cohérence optique) de la macula.
L’OCT est un examen non invasif : il est indolore et dure 5 minutes. Il est fait sur place.
Pour schématiser c’est un « scanner » de la macula qui en détaille les différentes couches.
Il confirme le diagnostic et met en évidence une récidive de la maladie.
C’est un examen incontournable dans le suivi.
La dernière étape consistera à voir le médecin qui pratiquera l’examen du fond d’œil à l’aide d’une loupe et analysera les clichés de l’OCT. En cas de DMLA humide, un traitement par piqure dans le blanc de l’œil (injection intra vitréenne= IVT) vous sera prescrit.
Pourquoi il est important de ne pas attendre : le traitement
Les injections intravitréennes d’antiVEGF permettent de stabiliser la maladie. Plusieurs molécules sont efficaces ; le ranimizumab (Lucentis®) et l’aflibercept (Eylea®). Une autre molécule devrait être commercialisée courant 2020. Le traitement est symptomatique, il ralentit l’évolution mais ne guérit pas la maladie.
Les IVT sont effectuées dans une salle propre, sous anesthésie locale ,après désinfection de l’oeil. Un traitement par larmes artificielles est conseillé dans les heures qui suivent l’injection. L’injection dure quelques secondes, elle est pratiquée par le médecin.
Le + de notre centre :
Une psychologue est présente sur place le jour des injections pour informer les patients et répondre à leur questions.
Le schéma thérapeutique débute par 3 injections (1 par mois pendant 3 mois). Un suivi mensuel est ensuite nécessaire pendant 6 mois. Si la maladie a récidivé une nouvelle injection est nécessaire. Si aucune récidive n’est notifiée pendant ces 6 mois, on espace le suivi et une consultation tous les 2 mois est alors possible.
En cas de récidive, le principal objectif est d’essayer de trouver l’intervalle de récidive de façon à limiter le nombre de consultation et de programmer les injections au moment opportun.
A la Clinique Trenel, les consultations et les injections sont réalisées sur place. Avec notre nouvelle organisation, et si vous devez être injecté suite à la consultation, nous pourrons vous proposer de l’être dans la foulée sans être obligé de revenir.
En cas de DMLA sèche, seules des mesures hygiéno-diététiques sont préconisées comme l’arrêt du tabac, la protection solaire et des compléments alimentaires.
Bien entendu, ces mesures sont aussi à prendre en cas de DMLA humide.
Dans certaines formes de DMLA, il vous sera proposé du laser PDT ou photothéapie dynamique à la Verteporfin en association aux injections. Là encore, la séance de laser est réalisée sur place. Une angiographie sera effectuée au préalable. Il s’agit d’un examen complémentaire qui consiste à injecter un produit de contraste (fluorescéine et/ou vert d’indocyanine) dans une veine du creux du coude puis prendre des clichés du fond d’œil afin de localiser la zone à lasériser.
DMLA : l’évolution
La DMLA est une maladie chronique qui peut passer d’une forme sèche à une forme humide et vice versa. C’est pourquoi une surveillance à vie est nécessaire.
Entre 2 rendez-vous, il est impératif de vous surveiller de la manière suivante : à raison d’une fois par semaine (par exemple, le dimanche matin au moment du petit déjeuner), mettez vos lunettes, cachez un œil et avec l’autre œil fixer un carreau de carrelage ou une ligne de page de votre journal. Vous pouvez aussi faire le test avec une grille d’amsler (ci-dessous). Si vous constatez des ondulations, vous devez prendre RDV.
Des applications d’autosurveillance existent sur smartphone, nous pourrons vous les prescrire en fonction du contexte.
La DMLA ne rend pas aveugle, elle dégrade le centre de la vision mais le champ visuel périphérique est conservé.
La rééducation basse vision
En cas de malvision, la rééducation basse vision peut être envisagée. Elle est pratiquée par une orthoptiste et peut vous être prescrite par l’ophtalmologiste.
Elle vise à optimiser les capacités visuelles restantes à l’aide ou non d’aides optiques. Elle permet de préserver la meilleure autonomie possible et favoriser une meilleure qualité de vie.